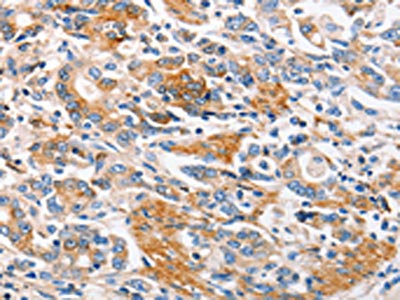

MC1R Antibody
-
中文名稱:MC1R兔多克隆抗體
-
貨號:CSB-PA122172
-
規格:¥1100
-
圖片:
-
The image on the left is immunohistochemistry of paraffin-embedded Human colon cancer tissue using CSB-PA122172(MC1R Antibody) at dilution 1/100, on the right is treated with synthetic peptide. (Original magnification: ×200)
-
The image on the left is immunohistochemistry of paraffin-embedded Human gastic cancer tissue using CSB-PA122172(MC1R Antibody) at dilution 1/100, on the right is treated with synthetic peptide. (Original magnification: ×200)
-
-
其他:
產品詳情
-
Uniprot No.:
-
基因名:
-
別名:CMM5 antibody; MC1 Receptor antibody; MC1-R antibody; MC1R antibody; Melanocortin 1 receptor antibody; Melanocortin 1 receptor (alpha melanocyte stimulating hormone receptor) antibody; Melanocortin receptor 1 antibody; Melanocyte-stimulating hormone receptor antibody; Melanotropin receptor antibody; MSH-R antibody; MSHR antibody; MSHR_HUMAN antibody; SHEP2 antibody
-
宿主:Rabbit
-
反應種屬:Human,Mouse
-
免疫原:Synthetic peptide of Human MC1R
-
免疫原種屬:Homo sapiens (Human)
-
標記方式:Non-conjugated
-
抗體亞型:IgG
-
純化方式:Antigen affinity purification
-
濃度:It differs from different batches. Please contact us to confirm it.
-
保存緩沖液:-20°C, pH7.4 PBS, 0.05% NaN3, 40% Glycerol
-
產品提供形式:Liquid
-
應用范圍:ELISA,IHC
-
推薦稀釋比:
Application Recommended Dilution ELISA 1:1000-1:5000 IHC 1:50-1:200 -
Protocols:
-
儲存條件:Upon receipt, store at -20°C or -80°C. Avoid repeated freeze.
-
貨期:Basically, we can dispatch the products out in 1-3 working days after receiving your orders. Delivery time maybe differs from different purchasing way or location, please kindly consult your local distributors for specific delivery time.
-
用途:For Research Use Only. Not for use in diagnostic or therapeutic procedures.
相關產品
靶點詳情
-
功能:Receptor for MSH (alpha, beta and gamma) and ACTH. The activity of this receptor is mediated by G proteins which activate adenylate cyclase. Mediates melanogenesis, the production of eumelanin (black/brown) and phaeomelanin (red/yellow), via regulation of cAMP signaling in melanocytes.
-
基因功能參考文獻:
- the association between particular MC1R alleles and the risk of skin cancers, was investigated. PMID: 29968341
- there is an association between TERT promoter mutations and MC1R variants in melanoma patients PMID: 27930874
- with regard to cutaneous malignant melanoma risk, no association found in the combination of GSTP1 Ile105Val with MC1R RHC-variant alleles [meta-analysis] PMID: 27304781
- In familial melanoma patients, the presence of MC1R R variants was associated with an increased prevalence of environmental risk factors and features associated with UV radiation-induced damage. PMID: 29405243
- In melanomas and for somatic C>T mutations, a signature linked to sun exposure, the expected single-nucleotide variant count associated with the presence of an R allele is estimated to be 42% (95% CI, 15-76%) higher than that among persons without an R allele. PMID: 27403562
- These data clearly show a new and hitherto unsuspected role for MC1R in noncutaneous solid tissues before birth. PMID: 29316344
- In both melanoma cell lines, alphaMSH determined the reduction of proliferation through the PI(4,5)P2/PLC pathway, employing PPARgamma as an effector element. These evidence could offer perspectives for new therapeutic approaches for melanoma. PMID: 29020973
- Carriage of any MC1R variant, one variant and two or more variants, compared with not having such variants was significantly associated with fair hair color, skin type I/II, and presence of freckles. PMID: 27251790
- key molecular events driving MC1R-mediated enhancement of genome maintenance and MC1R-induced pigment induction in melanocytes are distinct PMID: 28094871
- amino acid residue 128 in Transmembrane 3 (TM3) of MC1R, or amino acid residue L133 in TM3 of the MC4R, play crucial roles in ligand des-Trp(9)-NDP-alpha-MSH selectivity at MC1R or MC4R. PMID: 28579117
- In a heterologous expression system, MC1R-dependent Arrestins B ubiquitination was enhanced by overexpression of MGRN1 and was impaired by siRNA-mediated MGRN1 knockdown thus pointing to MGRN1 as the responsible E3-ligase. PMID: 28947386
- POMC and MC1R were significantly lower in vitiligo lesional skin than in non-lesional skin as well as in controls and they were significantly higher in non-lesional skin than in the skin of the controls. PMID: 26437741
- MC1R gene could modify the age of onset in Spanish Huntington's disease patients. PMID: 27924526
- results highlight a central role for MC1R palmitoylation in pigmentation and protection against melanoma PMID: 28869973
- MC1R variant p.V92M (rs2228479) was present in 72 (14%) patients and 15 (9%) controls and confers increased risk of developing late-onset Alzheimer's disease, especially in those patients whose genetic risk could not be explained by APOE genotype. This association remains and even increased in the subset of 69 patients with typical AD cerebrospinal fluid profile. No association was found between p.V92M and age of onset. PMID: 28059796
- MC1RR163Q is associated with a lower risk of complicated sepsis after trauma. Therapeutic targeting of MC1R may be beneficial for trauma patients at risk for complicated sepsis PMID: 27488084
- This study evaluated the association of perceived facial age with multiple single nucleotide polymorphisms in the MC1R gene. PMID: 27133870
- MC1R-positive basophils are present exclusively in the nasal mucosa of those AR patients who had undergone nasal allergen provocation 24 h before. PMID: 27196703
- MC1R genotype is associated with patient phenotypes with BRAF and NRAS mutations in melanoma PMID: 28842324
- MC1R mutation is associated with Melanoma. PMID: 28024115
- Melanocortin-1 receptor variants are associated with high melanoma risk. PMID: 27540956
- It was suggested to be involved in Parkinson disease (PD) and melanoma, but its genetic variants do not play roles in susceptibility for Parkinson disease or rapid eye movement sleep behavior disorder. PMID: 27131830
- Variants in MC1R do not play a major role in PD in the Chinese population. PMID: 27084066
- Latin American families had CDKN2A mutations more frequently (P = 0.014) than Spanish ones. Of patients with SMP, 10% of those from Latin America and 8.5% of those from Spain had mutations in CDKN2A (P = 0.623). The most recurrent CDKN2A mutations were c.-34G>T and p.G101W. Latin American patients had fairer hair and skin) and a higher prevalence of MC1R variants compared with Spanish ones PMID: 26681309
- MC1R genetic effects might contribute to sex-specific differences in skin phototype PMID: 27637409
- MC1R may represent a common pathogenic pathway for melanoma and Parkinson disease. PMID: 28019657
- Carriers of MC1R variants were at increased melanoma risk independent of their sun exposure. PMID: 27050141
- This study confirms the presence of CDKN2A and MC1R variants among Cypriot melanomas and supports existing evidence of a role for these variants in susceptibility to melanoma. PMID: 28360400
- Presence of MC1R variant alleles predicted higher levels of dental fear and fear of pain. Importantly, fear of pain mediated the relation between MC1R variant status and dental fear. PMID: 27555332
- this case-control genetic association study using Taiwanese population showed that certain linkage disequilibrium structure of MC1R is strongly associated with vitiligo PMID: 26670452
- Case Report: MC4R p.Met215del coexisting with FTO and MC1R gene variants, causes severe early onset obesity. PMID: 27394708
- MC1R status is associated with BRAF(V600E), BRAF(V600K), and NRAS mutations in cutaneous melanomas PMID: 26807515
- Study found that HBD2 bound tightly to Mc1r with an affinity similar to that of HBD3 PMID: 26536271
- Six MC1R mutations segregated with the phenotype in seven families, including a p.Val174del in-frame deletion and a p.Tyr298* nonsense mutation, that were analyzed for function in heterologous HEK293 cells. PMID: 26197705
- Even after taking into account potential confounding effects of MC1R genotype and various lifestyle factors that close relatives may share, family history of skin cancer remained strongly associated with early-onset basal cell carcinoma PMID: 26381319
- Woman who carried a deleterious CDKN2A mutation and was also homozygous for the MC1R variant allele R160W developed 20 cutaneous melanomas in her lifetime. PMID: 26103950
- The pattern of sequence diversity here does not support a model of strong selective constraint on MC1R in Northern Island Melanesia. PMID: 26482799
- Functional characterization of MC1R-TUBB3 intergenic splice variants of the human melanocortin 1 receptor has been undertaken in response to ultraviolet irradiation. PMID: 26657157
- none of the three variants of the MC1R gene and related haplotypes be associated with sporadic form of Parkinson disease in Chinese Han population from Mainland China. PMID: 26628245
- MC1R genotype is a risk factor for the development of BCC in Greek patients independently of pigmentary characteristics, and the combination of MC1R variants may modulate this risk. PMID: 25809071
- Interestingly, we observed an increased risk of melanoma in subjects with darker skin and lower nevus count, usually considered at low risk, when carrying melanocortin 1 receptor polymorphisms. PMID: 25736238
- MC2R and MC1R signals are consecutively required for the regulation of EPO signal transduction in erythroblast differentiation, and MC5R signal transduction is required to induce enucleation. PMID: 25860801
- MC1-signaling protects against cartilage degradation and subchondral bone sclerosis in OA indicating a beneficial role of the POMC system in joint pathophysiology. PMID: 25191747
- The presence of two common variants of MC1R was identified as a risk factor for severe photoaging. PMID: 26067307
- ASIP diminishes agonist-independent MC1R basal signaling whereas HBD3 is a neutral MC1R antagonist that blocks activation by melanocortins. PMID: 26168232
- the inhibitory effects of alpha-MSH on inflammation are dependent on MC-1 R PMID: 25898835
- Our results suggest inherited variation in MC1R may play an influential role in anatomic site presentation of melanomas and may differ with respect to skin pigmentation phenotype. PMID: 25790105
- The computational analysis proved capable of identifying the potentially damaging non-synonymous single nucleotide polymorphisms in MC1R. PMID: 25794181
- MC1R mutations in this series demonstrated and inverse association for head and neck melanomas. PMID: 25385688
- MC1R polymorphism is associated in patients with pot-burn hypertrophic scarring. PMID: 26030184
顯示更多
收起更多
-
相關疾病:Melanoma, cutaneous malignant 5 (CMM5)
-
亞細胞定位:Cell membrane; Multi-pass membrane protein.
-
蛋白家族:G-protein coupled receptor 1 family
-
組織特異性:Expressed in melanocytes. Expressed in corticoadrenal tissue.
-
數據庫鏈接:
Most popular with customers
-
-
YWHAB Recombinant Monoclonal Antibody
Applications: ELISA, WB, IHC, IF, FC
Species Reactivity: Human, Mouse, Rat
-
Phospho-YAP1 (S127) Recombinant Monoclonal Antibody
Applications: ELISA, WB, IHC
Species Reactivity: Human
-
-
-
-
-